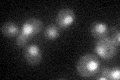
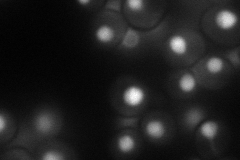
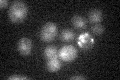

View description
S-phase checkpoint protein required for DNA replication; interacts with and stabilizes Pol2p at stalled replication forks during stress, where it forms a pausing complex with Tof1p and is phosphorylated by Mec1p; protects uncapped telomeres
Localization:
Intensity:
Fold change:
Significance:
-
C’ GFP library in SD
nucleus22.96 -
N' NOP1pr-GFP in SD
nucleus75.8653 -
N' TEF2pr-mCherry in SD

nucleus74.3156 -
N' NATIVEpr-GFP in SD

nucleus28.4425 -
N' TEF2pr-VC and Cyto-VN in SD

nucleus38.8654 -
C’ GFP library in SD+DTT

technical problem0N/ANo -
C’ GFP library in SD+H2O2

nucleus23.691.03No -
C’ GFP library in Starvation Media
nucleus19.680.85No -
C’ GFP library on the background of Pup2-DaMP

nucleus -
C’ GFP library on the background of CCT mutant

nucleus20.84650.907726No
